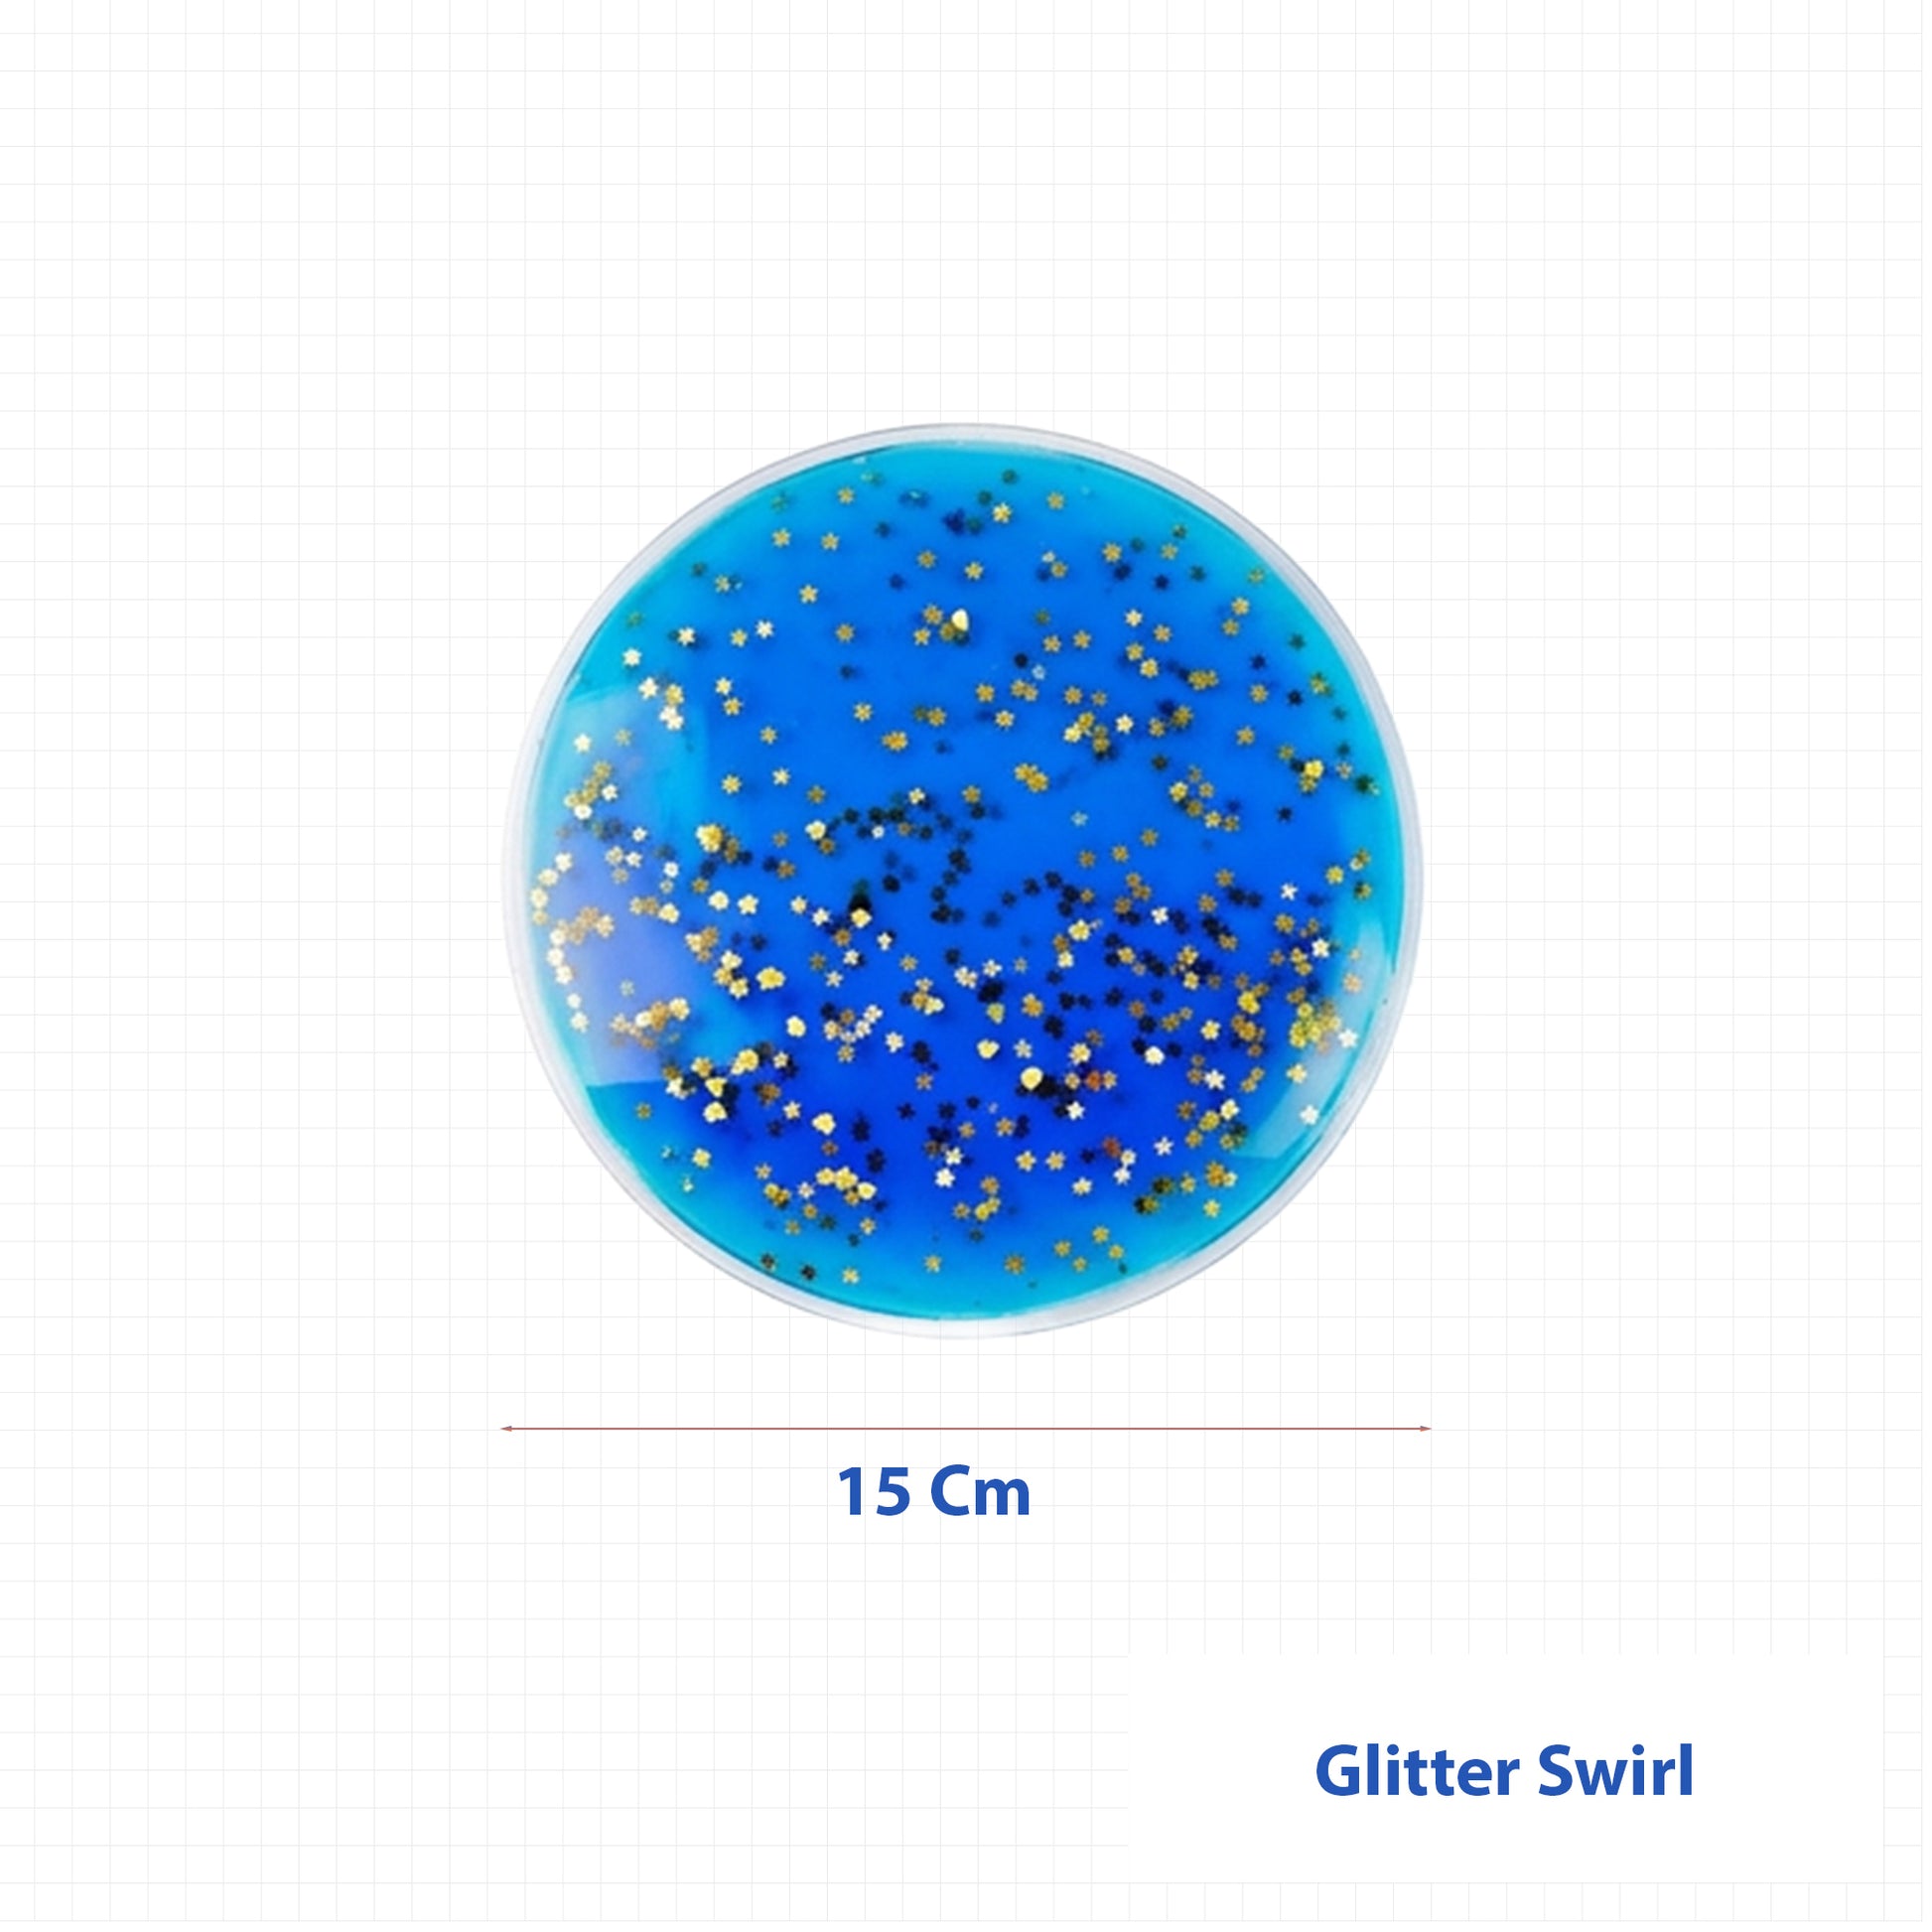

Abley's Liquid Fidgets, Glitter Swirl Visual Tool, 6-Pack brings sensory fun into your hands. This set offers a playful mix of colors and swirling glitter. The tactile feeling is satisfying. Each disc is easy to grip. The movement inside creates soothing patterns. These liquid fidget sensory toys are great for children and adults. They can calm busy hands. They draw attention and help with focus.
The 6-pack set lets you switch colors. Every disc is filled with liquid and bright glitter. These liquid fidget sensory toys are strong. The material resists daily squeezing. They work for classrooms and therapy sessions. Use them during breaks or quiet time. Many people find the swirling effect relaxing. The toys are safe and non-toxic.
Abley's designs each tool with care. Needs of users come first. Their liquid fidget sensory toys suit many situations. Children with sensory needs enjoy them. Adults can use them at work or at home. The portable size means you can carry one in a bag. Use them while traveling or waiting. The swirling glitter is visual and calming.
Teachers can add liquid fidget sensory toys to their toolkit. They work well during group activities. They also help during solo play. The smooth edges are gentle on skin. These toys require no batteries. There is no mess with careful use.
This pack from Abley's supports sensory self-regulation. People use them to reduce stress. Bright colors catch the light. The swirling liquid glitters shift with movement. These liquid fidget sensory toys offer both play and relaxation. The design is simple. The benefit is real. Keeping hands busy helps minds stay focused.
If you have any questions about this product, please let us know by filling out the form below, and we will contact you as soon as possible.